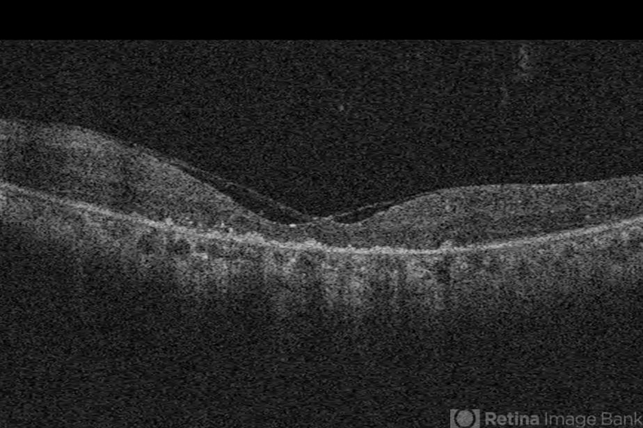

-
 By John S. King, MD
By John S. King, MD
Retina Associates, PA - Uploaded on Jun 29, 2014.
- Last modified by Caroline Bozell on Jun 30, 2014.
- Rating
- Appears in
- Miscellaneous
- Condition/keywords
- usher's syndrome
- Photographer
- Wayne A Ladlee Jr
- Imaging device
-
Optical coherence tomography system
Cirrus - Description
- Ushers 2.

Initializing download.
Initializing download.









